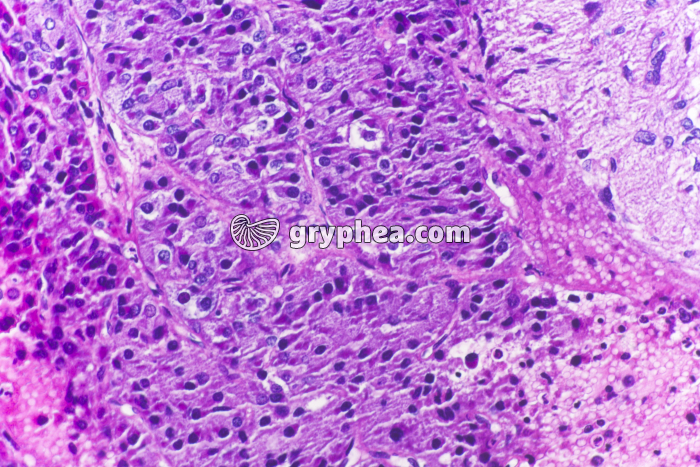
Hypophyse médiane x100 - gryphea.com

1 crédit = 6.00€ TTC
(Hors pack)
si vous êtes enseignant, le site gryphea.org a été conçu spécialement pour vous !
L’hypophyse est une petite glande située à la base du cerveau chez les Vertébrés, responsable de la synthèse et de la sécrétion de plusieurs hormones influant sur l’activité métabolique et hormonales d’autres organes du corps. Elle dépend elle-même des sécrétions de neuro-hormones produites par une autre partie du cerveau, située juste à proximité, l’hypothalamus.
L’hypophyse est subdivisée en plusieurs lobes :
l’hypophyse antérieure, ou adénohypophyse
l’hypophyse intermédiaire, ou médiohypophyse
l’hypophyse postérieure, ou posthypophyse
Le lobe intermédaire de l’hypophyse est moins développé chez l’Homme que chez d’autres mammifères, et ne consiste qu’en quelques glandes pseudovésiculaires, dont les cellules pourraient synthétiser de petites quantités de MSH ou d’endorphines.
La suite du commentaire est réservée aux inscrits, créez un compte gratuitement.